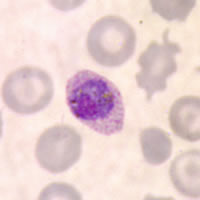
P. ovale gametocytes in a thin blood smear
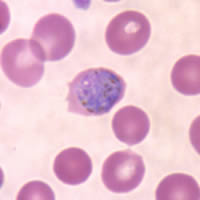
P. ovale gametocytes in a thin blood smear

|
|
[Last Modified: ] |
|
|
|
| [Plasmodium
falciparum] [Plasmodium malariae] [Plasmodium ovale] [Plasmodium vivax] |
|
Plasmodium ovale: Gametocytes
Smears from patients:
Plasmodium ovale gametocytes are round to oval, and may almost fill the red blood cells (RBCs). Pigment is brown and more coarse than that of P. vivax. RBCs are normal to slightly enlarged (1 1/4 ×), may be round to oval, and are sometimes fimbriated. Schüffner's dots are visible under optimal conditions.
|
 |
|
| A | B | c |
A, B, C: Gametocytes in thin blood smears. The Schüffner's dots can be seen in the infected oval RBC in A, and the erythrocytes in B and C show fimbriation.
|
||||||||